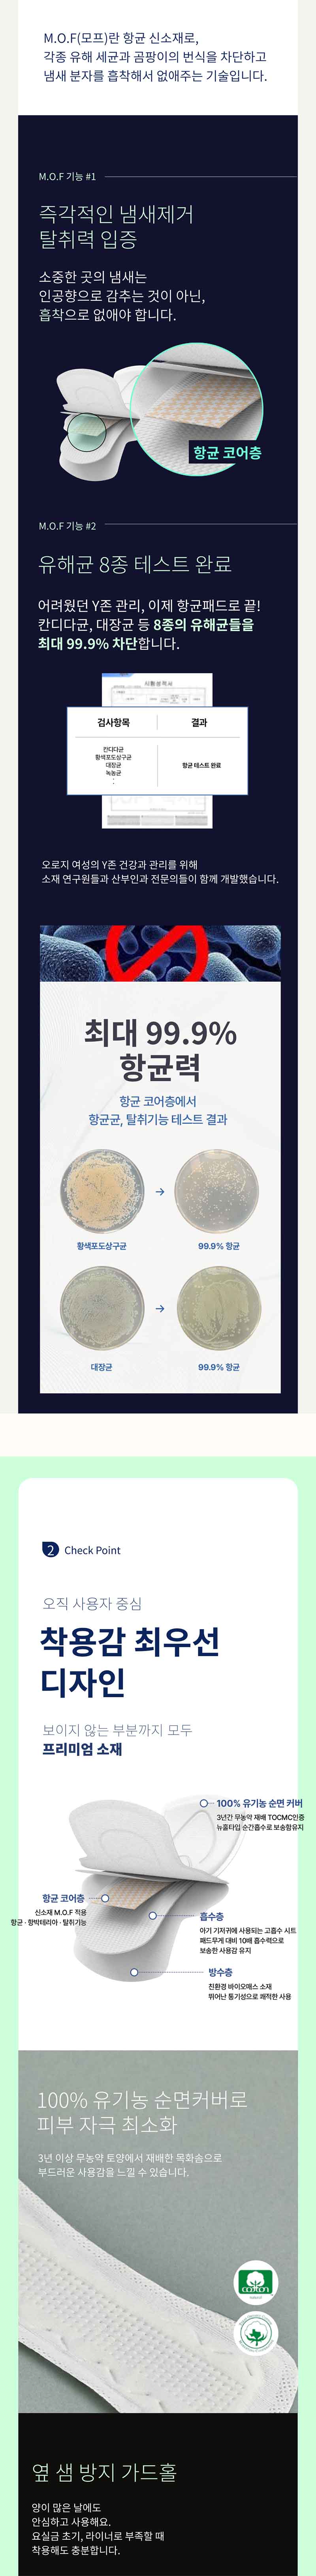

카테고리 보기
브랜드관
- 구매문의
- 02- 737-3327
- ✓ 이 전화번호는 구매 고객 전용입니다. ※ 타 쇼핑몰 구매 상품 A/S 전화 문의 사절
- 입금계좌안내 은행 및 예금주를 확인해주세요
- 1005-802-731216
- 은행명 : 우리은행 / 예금주 : 한광준(CNS코리아)
- 공지사항 더보기
- ✓ 봄맞이 프로모션2026-03-07
- ✓ 2026년 3월 카드사 무이자 할부 혜택 안내2026-02-28
- 탑셰프 전체 상품 주문 마감2026-02-06
- 2026년 2월 카드사 무이자 할부 혜택 안내2026-02-02
-
CNS코리아 대표자 : 한광준 서울특별시 서초구 사임당로8길 13, 4402-L704호(서초동, 제일빌딩)
사업자등록번호 : 635-02-00042 사업자정보확인 통신판매업신고 : 제 2026-서울서초-0020 호
고객센터 : 02- 737-3327 FAX : Email : scm@cnskorea.net
개인정보보호책임자 : 한광준 (scm@cnskorea.net)CNS코리아의 사전 서면 동의 없이 사이트의 일체의 정보, 콘텐츠 및 UI등을 상업적 목적으로 전재, 전송, 스크래핑 등 무단 사용할 수 없습니다.
Copyright ⓒ CNS코리아 All rights reserved.
-
에스크로 구매안전서비스
고객님은 안전거래를 위해 현금으로 5만원이상 결제시 구매자가 보호를 받을 수 있는 구매안전서비스(에스크로)를 이용하실 수 있습니다.
보상대상 : 미배송, 반품/환불거부, 쇼핑몰부도